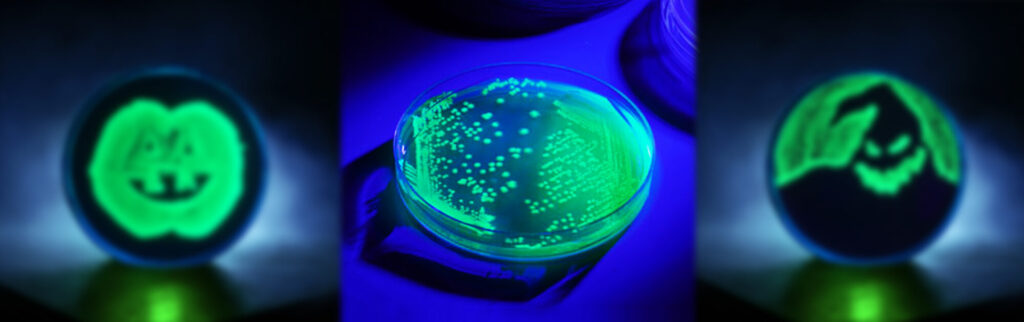

Lors de l’identification des pathogènes, les microbiologistes du domaine de la sécurité alimentaire doivent faire face aux contaminations croisées des souches de contrôle, une cause fréquente de faux positifs.
C’est pourquoi la règlementation américaine (USDA et FDA), recommande l’utilisation de souches de contrôle avec des marqueurs de protéine fluorescente verte (GFP) afin de distinguer clairement les témoins de la véritable contamination. En effet, ces souches sont fluorescentes sous la lumière UV ce qui permet d’éliminer toute incertitude quant à leur origine.
Avec les souches de contrôle UV-BioTAG, le marqueur GFP est intégré dans le chromosome plutôt que dans le plasmide pour une meilleure stabilité. Pour avoir un aperçu de l’utilisation quotidienne de ces souches de contrôle en laboratoire, notre partenaire Microbiologics a interviewé Dan DeMarco. Ph.D., directeur scientifique d’Eurofins Microbiology Laboratories (EML – Louisville / Kentucky).

Comment vos procédures de laboratoire ont-elles changé depuis que vous avez commencé à utiliser les contrôles GFP ?
Rien de substantiel n’a changé dans nos laboratoires de production. Nous avons toujours souligné et continuons de souligner l’importance d’inclure des contrôles positifs. Les contrôles positifs sont le seul moyen de vérifier de façon routinière que les méthodes utilisées par le laboratoire donnent les résultats que nous attendons. Nous continuons à suivre les meilleures pratiques en matière de formation et d’hygiène. Cependant nous avons maintenant une confiance beaucoup plus grande, parce que nous pouvons dire instantanément quand nous examinons la souche de contrôle.

Qu’est-ce qui, dans l’UV-BioTAG™ en particulier, a facilité ou a amélioré votre confiance dans vos processus de contrôle qualité ?
Les plus grands avantages sont la rapidité et la confiance dans le résultat. Auparavant, bien que nous utilisions des souches rares pour nos contrôles quotidiens, on ne pouvait jamais dire avec certitude si une souche donnée était apparue naturellement ou si elle était le résultat d’une contamination au sein du laboratoire. Comme la GFP n’est pas présente dans la nature, un résultat positif pour sa présence est absolu. De plus, il fallait auparavant recourir à la sérologie ou au typage moléculaire lors de la recherche d’une éventuelle contamination par une souche témoin. Ces techniques peuvent prendre des heures ou des jours. Avec les UV, il suffit de quelques minutes pour obtenir une réponse.
👉 Vous souhaitez en savoir plus sur les souches UV-BioTAG ? Contactez-nous dès maintenant :
Contact :
« * » indique les champs nécessaires
